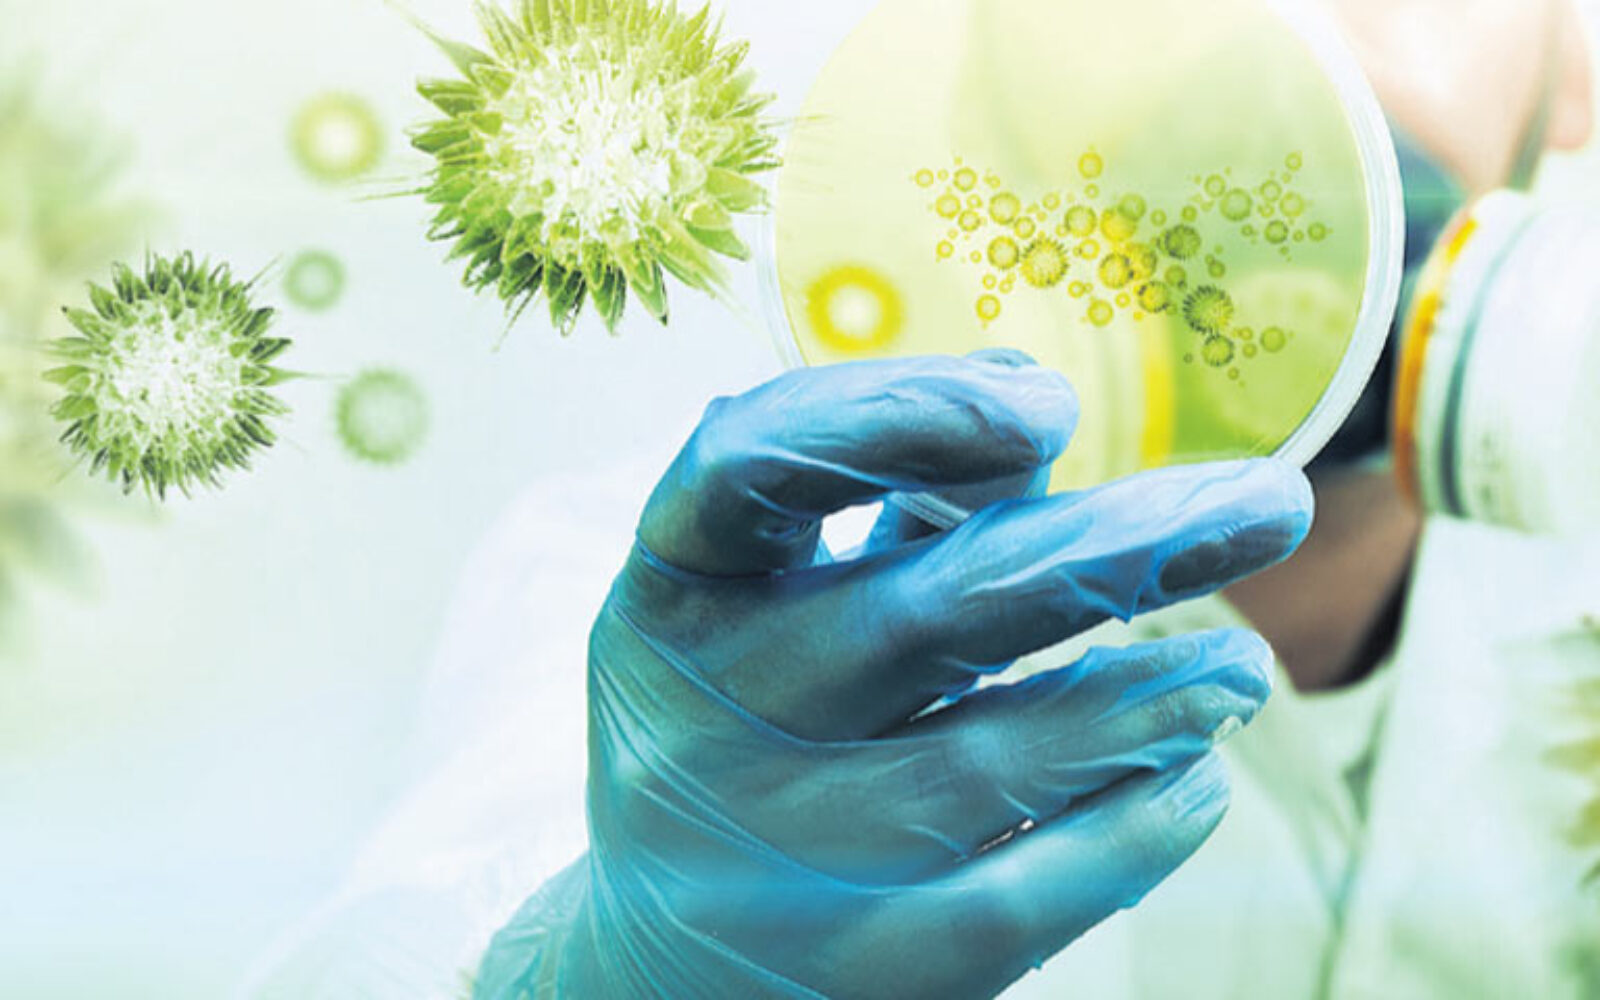

Znanstvenica Instituta Ruđer Bošković, dr. Mariastefania Antica postala je partner na multidisciplinarnom projektu THYMISTEM u sklopu sheme 'Zdravlje' Sedmog okvirnog programa Europske unije vrijednom 6 milijuna eura, od čega 500 tisuća pripada IRB-u, objavio je Institut.
Kako pojašnjavaju u Ruđeru, riječ je o projektu koji okuplja institucije i stručnjake u području biologije i imunobiologije iz šest europskih zemalja i SAD-a, koji će tijekom sljedeće četiri godine razvijati metode za uzgoj stanica matica timusa kako bi u budućnosti omogućili obnovu tkiva timusa i imunosnog sustava ljudi. Cilj projekta je razviti terapiju stanicama maticama koje mogu obnoviti imunosni sustav tako što će popraviti timus, organ koji se nalazi u prsnom košu iznad srca i koji je zadužen za proizvodnju važnih obrambenih stanica organizma.

Važna obavijest:
Sukladno članku 94. Zakona o elektroničkim medijima, komentiranje članaka na web portalu Poslovni.hr dopušteno je samo registriranim korisnicima. Svaki korisnik koji želi komentirati članke obvezan je prethodno se upoznati s Pravilima komentiranja na web portalu Poslovni.hr te sa zabranama propisanim stavkom 2. članka 94. Zakona.Uključite se u raspravu